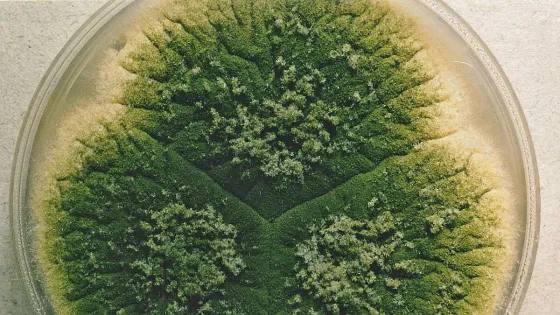
Aspergillus_parasiticus_UAMH3108-v1

- Ученые Казанского научного центра РАН и коллеги из Апатитов доказали способность плесневых грибов-аспергиллов нейтрализовать высокотоксичное промышленное соединение - трибутилфосфат.
- Это открывает путь к созданию экологичных биотехнологий для очистки сточных вод и загрязненных почв.
- ТБФ широко используется в ядерной энергетике, горнодобывающей и химической промышленности, но относится к высокотоксичным органофосфорным соединениям.
- Ранее разлагать его биологическим путем могли только бактерии.
- Ученые исследовали два штамма черного аспергилла (Aspergillus niger) и установили, что оба штамма способны расти в присутствии ТБФ, но их реакция на загрязнитель существенно различается.
- Один из штаммов - Aspergillus niger F-4816D - продемонстрировал повышенную устойчивость к токсиканту и возможную способность использовать трибутилфосфат как источник фосфора.
- В отличие от него, исходный штамм Aspergillus niger F-4815D оказался значительно более чувствительным к ТБФ.
- Практическое значение исследования заключается в возможности создания биотехнологий очистки сточных вод и почв от трибутилфосфата и сходных органофосфорных загрязнителей.
«Практическое значение исследования заключается в возможности создания биотехнологий очистки сточных вод и почв от трибутилфосфата и сходных органофосфорных загрязнителей. В настоящее время биологическое обезвреживание токсичных отходов набирает популярность. Этим методам очистки с каждым годом поддается все большее число токсичных поллютантов. В отличие от химических методов нейтрализации, биологические подходы отличаются экологической безопасностью и могут быть применимы для рекультивации промышленных территорий и очистки техногенных водоемов», - отметили в пресс-службе.